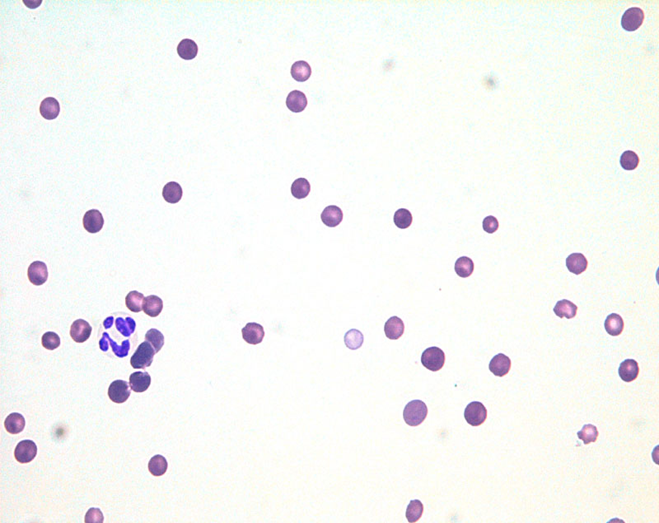

フェレットは、避妊手術を受けていない雌のエストロゲン誘発性貧血、外傷性出血、自家免疫性溶血性貧血など、重度の貧血を呈する様々な病態に罹患することが知られています 。これらの緊急性の高い病態において、輸血は患者の命を救うための重要な治療手段となりえます 。しかし、犬や猫の輸血医療と比較すると、フェレットの輸血に関する知識や体制はまだ十分に確立されていないのが現状です。特に、血液の保存に関する研究は限られており、組織的な血液バンクプログラムも存在しないため、緊急時に迅速かつ安全に輸血を行うための具体的な指針が求められています。

輸血の適応と種類
輸血の臨床的適応
輸血の決定は、単に検査結果の数値に基づいて行われるべきではなく、患者の総合的な臨床状態を評価した上での判断が不可欠となります。赤血球容積率(PCV)は輸血の必要性を示す重要な指標の一つであり、一般的にPCVが15%を下回る場合、輸血が強く推奨されています。しかし、PCVが10%と極めて低い場合であっても、慢性的な貧血で身体が徐々に適応しているフェレットは、臨床的に安定していることがあります〔Pignon et al.2014〕。一般的に貧血に起因する症状は、歯茎の蒼白、無気力、頻呼吸、運動不耐性などが含まれます。 具体的に輸血が推奨される主な病態は以下の通りになります。
- エストロゲン誘発性再生不良性貧血: 避妊手術を受けていない雌フェレットの持続的な発情期に生じ、骨髄での赤血球産生が低下し、重度の貧血や血小板減少を引き起こす 。
- 腫瘍、外傷や手術後の出血: 外傷性腹腔内出血や、肝臓や脾臓の出血性腫瘍(脾臓血腫)による急性出血は、輸血を必要とする緊急事態となりうる 。
- 自家免疫性溶血性貧血(IMHA)および赤芽球癆(PRCA): 免疫系が自身の赤血球を誤って破壊する疾患であり、輸血による支持療法が不可欠となる。
- 重度血小板減少症: 血小板数が30,000/μL未満に低下した場合、出血傾向が増し、輸血が必要となることがある 。ただし、免疫介在性血小板減少症の場合、輸血された血小板も速やかに破壊されるため、その効果は限定的である。
輸血の種類と特徴
フェレットにおける輸血方法は、ドナーの種別により主に三つの種類に分けられます。緊急時におけるこれらの選択肢は、利用可能なリソースに応じて戦略的に優先順位をつける必要があります。
同種輸血(Ferret-to-Ferret)
最も理想的な輸血方法であり、最も一般的に行われています 。フェレットには犬や猫のような明確な血液型システムが知られていないため、通常、交差適合試験(クロスマッチ)は必要ないとされ、輸血反応も稀であると考えられています 。この特性により、ドナーフェレットが迅速に確保できれば、手間のかかる前処理なしに輸血を実施できます。
異種輸血(Cross-Species)
ドナーフェレットが利用できない緊急時に、最後の手段として考慮される代替療法になります 。海外の臨床報告では、ネコやイヌの赤血球濃厚液を用いた異種輸血の成功例が報告されている 。しかし、異なる種の血液を用いるため、免疫学的反応のリスクが常に伴います。 肝腫瘤に起因する腹腔内出血と診断された飼いフェレットに対し、A型ネコ赤血球パック(pRBC)による異種輸血を行った報告もあり、一過性の高ビリルビン血症を特徴とする遅発性輸血反応と推定される症状が発現しましたが、6カ月後の再検査では、フェレットの臨床状態は良好でした〔Sato et al.2020〕。なお、フェレットは、イヌとネコの赤血球と交差適合試験を実施したところ、興味深いことに、全てのフェレットはイヌ赤血球とは適合しましたが、ネコ赤血球とは不適合が検出された結果がでています〔Tan et al.2023〕。
自己輸血(Patient’s Own Blood)
生命を脅かす腹腔内出血や胸腔内出血を伴う患者に対して、自身の血液を再利用する革新的な方法です。この方法は、出血した血液を無菌的に採取し、フィルターを通して患者に戻すことで、ドナーの確保が困難な緊急時でも迅速に対応できる利点があります。外傷性腹腔内出血の管理において、安全かつ効果的な選択肢であるとの報告があり、輸血反応も認められていません〔Su et al.2024〕。この方法は、出血部位が明確で無菌的に採取できる場合に、最も迅速かつリスクの低い輸血手段となりえます。
輸血プロトコルと手技
ドナーおよび血液の選定基準
輸血の成功には、健康なドナーの選定が極めて重要です。理想的なドナーフェレットは、体重が1kg以上で、年齢が5歳未満の健康な個体になります 。一般的に、体重が重い雄の方がより多くの血液を安全に採取できるため、ドナーとして好ましいとされます 。また、病歴(特にエピゾーティックカタル性腸炎など)や、過去の輸血歴、心臓病の有無、そして落ち着いた性格も重要な選定基準となります。 輸血用血液の適切な採取量は、フェレットの総血液量を考慮して決定されます。フェレットの循環血液量は、体重1kgあたり約75mLと推定され、健康なドナーから一度に安全に採取できる血液量は、全血液量の約10%までとされており 、これは体重1kgのフェレットで約7.5mLに相当します〔Hohenhaus 2004〕。重度なフェレットが対象でも、ほぼ大きさが同じフェレットからは、大量に採血することはできないこも欠点じなります。正式な輸血量は下記のような計算式で算出しますが、一度に大量の血液が採取できないことから、最大7~8mLの輸血をすることが一般的です。
輸血量(ml)=体重(kg)× 75 ml/kg * (目標 PCV受血動物 PCV) / 血液製剤 PCV
血液型と適合性
多くの哺乳類種において、赤血球表面には遺伝的に決定された様々な抗原が存在し、これが血液型システムを形成しています。例えば、イヌでは犬赤血球抗原(DEA)式と呼ばれる8種類の血液型が知られており 、ネコではAB式に基づきA型、B型、AB型の3種類が存在します 。これらの血液型は、それぞれ異なる赤血球抗原と、それに対する自然に獲得された、または過去の輸血によって産生された抗体によって定義されます。したがって、輸血を実施する際には、受血者と供血者の血液型を正確に判定し、重大な輸血反応を回避するためのクロスマッチング試験が必要となります。 これに対し、フェレットの血液学的特徴は他の一般的な動物種とは著しく異なっています。複数の文献において、フェレットには既知の血液型が存在しないことが示唆されています 。これは、フェレットが他の哺乳類が持つような多様な赤血球抗原システムを欠いていることを意し、実際に、212頭のフェレットを対象とした研究では、ランダムにペアにした血清と赤血球間で、自然に獲得された血液型抗体の証拠は検出されなかったことが報告されています。また、6組のフェレット間で血液を相互に輸血しても、赤血球抗体は検出されませんでした。これらの研究は、フェレットにヒトや他の哺乳類のような血液型が存在しないか、あるいは抗原システムが非常に弱く、検出可能な反応を引き起こさない可能性を示唆しています。このため、輸血はクロスマッチング(輸血前に行う血液適合性検査)なしでも臨床的にほとんどリスクがないと結論付けられています〔Manning et al.1990〕。
血液処理
輸血に用いる血液は、採取時に凝固を防ぐために適切な抗凝固剤と混合する必要があります。最も推奨されるのはCPDA(クエン酸-リン酸-ブドウ糖-アデニン)であり、これらは血液10mLに対して1~2mLの割合でシリンジに予め充填しておくことが推奨されます 。これらの抗凝固剤が利用できない場合は、ヘパリンを代替として使用することも可能です。
血液の採取と保存
多量の血液を採取する場合、頸静脈と前大静脈が主要な採血部位として用いられていますが、特に前大静脈からの採血は、熟練した技術を要する「盲目的」な手技ですが、多量の血液を迅速に採取する上で好ましい部位になります。フェレットの血液の保存には、犬や猫とは異なる重要な課題が存在します。フェレットの血液は保存中の劣化が非常に早く、特に抗凝固剤(CPDA)を用いた場合、保存開始後7日目には生化学的および形態学的変化(pH、グルコース、ナトリウムの低下と、乳酸、カリウムの増加、赤血球の変形など)が顕著になります。これは、イヌやヒトの血液よりも速い速度で起こる現象で、CPDAで保存されたフェレットの血液は、7日以上経過したものは輸血に用いるべきではないとされています〔Pignon et al.2014〕。 この極めて短い保存期間が、犬や猫のような組織的な血液バンクプログラムがフェレットで確立されていない主な理由です 。このため、フェレットの輸血は、事前に準備された血液製品に頼るよりも、緊急時に健康なドナーを確保し、採血後4時間以内に輸血を完了する といった「新鮮な血液」の利用に重点が置かれる傾向にあります。
輸血プロセスとモニタリング
輸血は、患者の静脈内(IV)または骨内(IO)ルートを通じて、18μmの血液フィルター(例:Hemo-Nate)を使用して投与されます 。循環器系の過負荷や輸血反応を防ぐため、輸血はゆっくりと慎重に投与することが理想ですが、赤血球を含む製剤は、細菌汚染と増殖を防ぐために4時間以内に投与を完了する必要があります。輸血中は、患者に重篤な急性アレルギー反応や免疫反応が発生する可能性があるため、厳密なモニタリングを行います。輸血反応は、血液型抗原以外の要因(例えば、血漿タンパク質や白血球、血小板に対する抗体反応など)によっても引き起こされる可能性があるため、輸血中の患者のモニタリングは依然として不可欠です。
輸血反応
フェレットには明確な血液型が存在しないと考えられているため、緊急時の輸血はクロスマッチングなしでも比較的安全に行えるとされています。しかし、これはあくまで「リスクが低い」というだけであり、絶対的な安全性を示すものではありません。血液製剤の保存状態や、輸血後の溶血反応のリスクなど、輸血処置には他の要因も関わってきます。フェレットにおける輸血反応の頻度は「不明」とされていますが 、これは単に反応が稀である可能性だけでなく、軽度な反応が見過ごされている可能性もあります。異種輸血では、ネコの血液を用いた事例で、一過性の高ビリルビン血症という遅発性の輸血反応が報告されています〔Sato et al.2020〕。
合併症の診断と対処法
輸血中に発生しうる合併症は、免疫介在性と非免疫介在性に大別される。免疫介在性の反応は、発熱、嘔吐、顔面浮腫などの軽度なものから、血管内溶血、ショック、呼吸困難などの重篤なものまで多岐にわたります。一方、非免疫介在性の合併症には、細菌汚染や、輸液速度が速すぎることによる循環器系の過負荷(心不全)などが含まれます。輸血反応が疑われる場合、直ちに輸血を中止し、対症療法を開始する必要があります 。具体的には、輸液療法で血圧を維持し、腎臓の灌流を確保します 。アナフィラキシー反応にはエピネフリン、非アナフィラキシー性のアレルギー反応には抗ヒスタミン剤の投与が検討されます 。さらに、重篤な反応では、副腎皮質ステロイドやドーパミンの使用も提唱されています。
輸血に付随する臨床的課題
フェレットの輸血治療には、血液型以外の複数の臨床的課題が存在します。第一に、輸血前に患者を鎮静・麻酔する場合、吸入麻酔薬であるイソフルランの使用が一時的にヘマトクリット値を低下させることがあり、これにより輸血の必要性を過大評価する可能性があります。 第二に、高エストロゲン症などによる貧血では、骨髄が回復するまでに数週間かかることがあり、単回の輸血では不十分で、複数回の輸血が求められる場合があります。これらの課題は、輸血プロトコルを遂行する上で、臨床医が包括的な視点を持つことの重要性を示しています。
参考文献
- Hohenhaus AE.Transfusion medicine in exotic pets.Compendium on Continuing Education for the Practicing Veterinarian26(1):40-49.2004
- Manning DD,Jackson LR,Fox JG.Lack of detectable blood groups in domestic ferrets: implications for transfusion.Journal of the American Veterinary Medical Association197.1:84-86.1990
- Pignon C et al.Assessment of a blood preservation protocol for use in ferrets before transfusion.Veterinary Record174(8):205.2014
- Saito M et al.Successful xenotransfusion in a domestic ferret with spontaneous hemoperitoneum using feline packed red blood cells. Journal of Veterinary Emergency and Critical Care30(2):213-219.2020
- Su AQ,Vardanega MJ,Johnson JA,Spelman LH.Autotransfusion for traumatic hemoperitoneum in four ferrets.Journal of the American Veterinary Medical Association.2024
- Tan T,Langlois I,Blais MS.Investigation of in vitro Blood Compatibility of the Domestic Ferret(Mustela putorious furo)with Feline and Canine Blood.Journal of Exotic Pet Medicine48(3).2023
